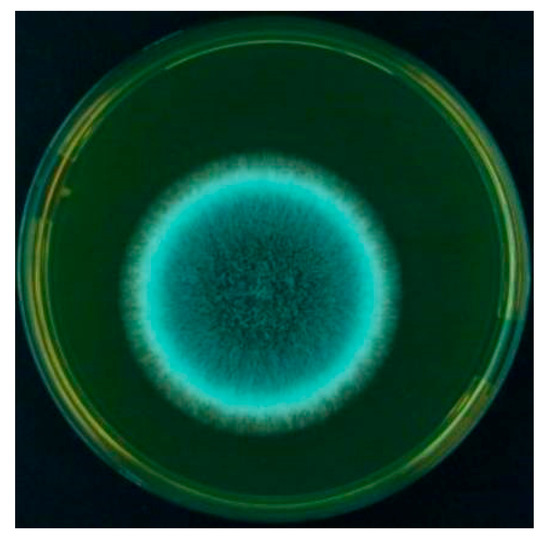
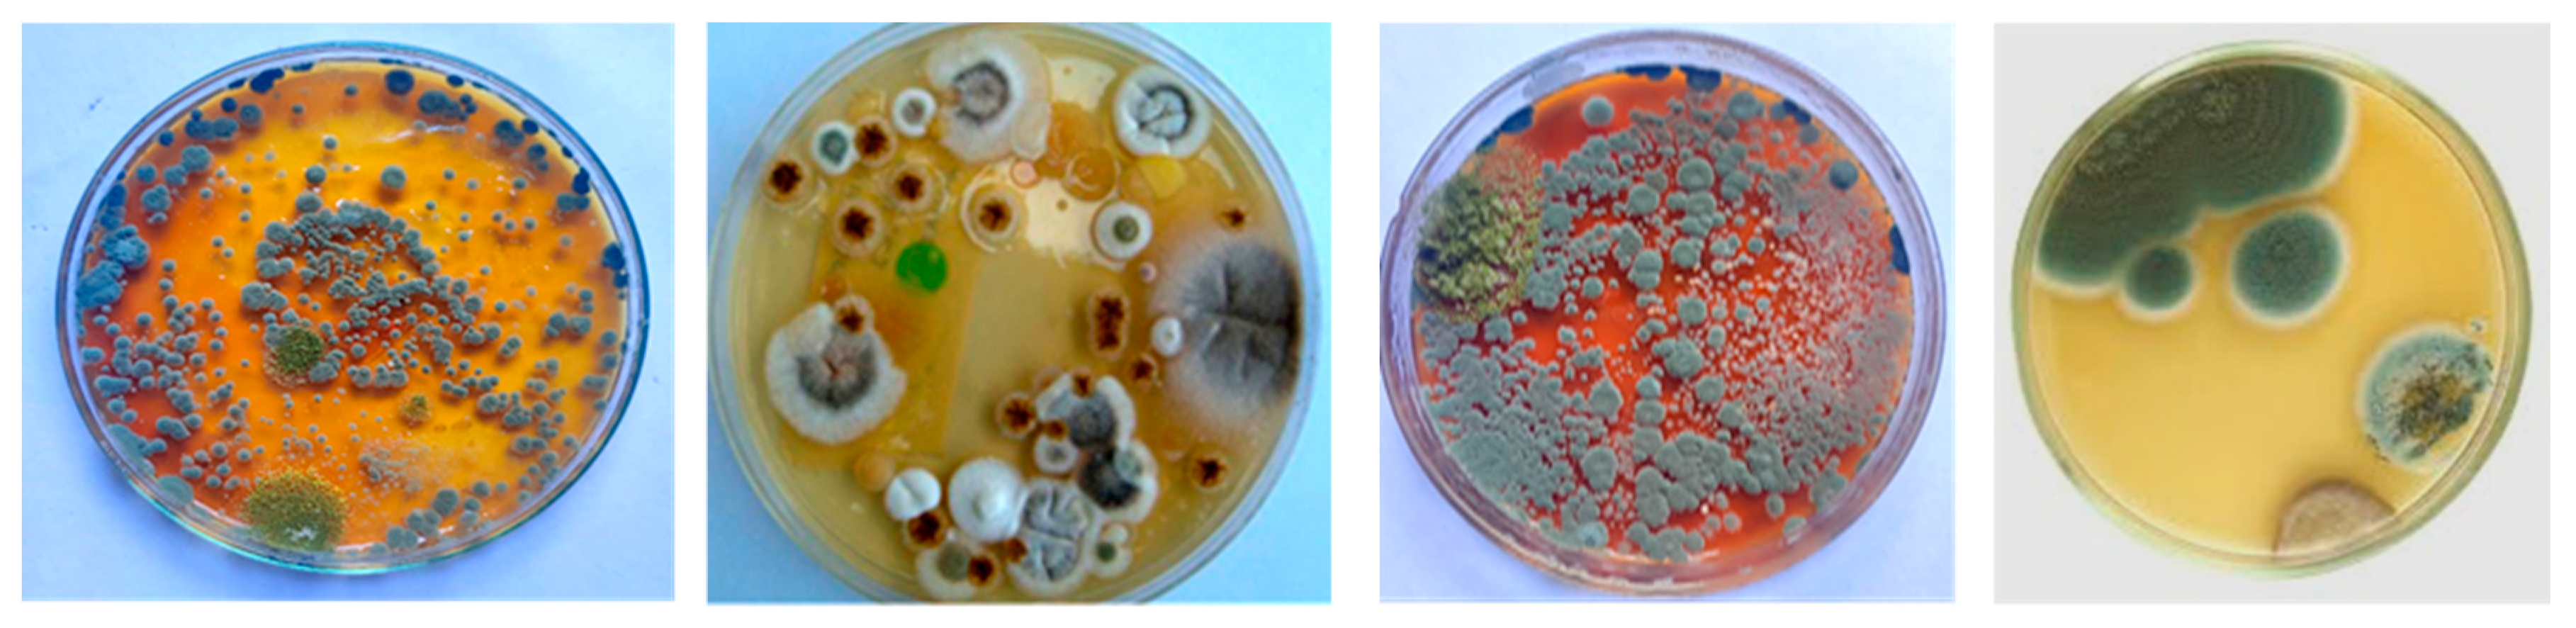
Aerobiology 04 00003 g002

Abstract
Aeromycoflora present in the library environment is known to play a significant role in triggering allergies and contributing to the deterioration of both cellulosic and non-cellulosic materials within the intramural setting of the Midnapore College Library. Fungal spores not only accelerate the aging and degradation of books but also pose considerable health risks to students, library visitors, and staff. In total, 480 fungal colonies belonging to 15 genera and 28 species were recorded using the culture plate exposure method. The predominant taxa included Aspergillus/Penicillium, Alternaria alternata, Alternaria solani, Cladosporium cladosporioides, Curvularia lunata, Penicillium oxalicum, Epicoccum sp., Fusarium solanii, Fusarium oxysporum, Periconia sp., Rhizopus sp., and other Penicillium species. Many of these fungi are well-documented allergens and have been reported to cause adverse health manifestations—such as respiratory discomfort and skin irritation—among students, teaching staff, and book handlers exposed to airborne mycobiota. The present study aimed to investigate the aeromycological diversity within the Midnapore College Library and to conduct immuno-clinical assessments to identify specific serum IgE using both in vivo and in vitro diagnostic techniques. Individuals frequently visiting the library reported symptoms including eye irritation, headaches, itchy skin, sore throat, and severe asthma. Spearman’s rank correlation analysis revealed a significant association between total and dominant spore concentrations and the health status of affected individuals. Clinico-immunological evaluations confirmed the allergenicity of Aspergillus fumigatus, with 39.5% of atopic individuals showing positive reactions in skin prick tests (SPT). Additionally, three novel sero-reactive proteins were identified, offering valuable insights for local clinicians in diagnosing and managing fungal-induced allergic conditions.
1. Introduction
The library is a basic source of cellulosic substrate for the proliferation of diverse groups of fungal organisms, provided an ambient climate of temperature and humidity. Aeromycoflora from libraries is known to be significant in relation to allergies and also causes the deterioration of cellulosic and non-cellulosic library materials. Airborne fungal spores in bio-aerosols play a crucial role in the degradation of valuable books and journals, which serve as a primary source of cellulose for the growth of various fungal organisms. This occurs at ambient temperature and humidity levels in the indoor environment of the Midnapore College Library. These fungal spores not only contribute to the aging and deterioration of books but also pose significant health risks to visiting students in the reading room and library staff, leading to serious allergic and respiratory issues.
Since time immemorial, libraries have been a repository of knowledge from great thinkers. Libraries are collections of important books, manuscripts, archives, and maps that preserve human knowledge and cultural history [1,2,3,4]. Biodeterioration of library materials is a major issue throughout the world [5,6,7]. The ingredients used in the paper-making industry, such as wood (cellulose), proteins, and chemical additives, are suitable substrates for bacterial and fungal growth [8,9,10,11,12,13,14,15,16]. Environmental variables such as heat, light, humidity, and dust, as well as biological factors such as bacteria, fungi, and insects, all contribute to the degradation and discoloration of books and manuscripts housed in libraries [17,18,19]. In favorable conditions, fungi thrive and damage books by destroying cellulose and decomposing binding materials, leather, plastics, and so on [6]. Seasonal variations in meteorological conditions cause variations in the concentration and composition of fungi [20]. According to Bankole OM (2010) [7], fungi are one of the main causes of the biodeterioration of library books. Fungi reproduce by both asexual and sexual means, and their spores, as well as conidia, form the component of airspora inside the library.
There are 20 thousand to 2 million fungal spores in 1 m3 of air. These spores can sprout and grow if they obtain the required moisture and heat. Generally, fungi grow in a temperature range of 15–35 °C. The most common fungi that grow on paper are Aspergillus and Penicillium sp. [21]. Deterioration of library material due to fungal and bacterial growth is a global problem and a cause of extensive damage to precious books and manuscripts [22]. Microfungi, which produce large numbers of spores, can be easily transported by bioaerosols in the external and internal atmosphere and can contaminate all kinds of surfaces. Inhalation of fungal spores dispersed from moldy books during handling is common in libraries. The occurrence of allergic disorders among library workers is well documented.
Fungal spores, pollen grains, and other airborne bioparticulate materials can cause various adverse health effects in humans, including hypersensitivity reactions, infections, and allergic disorders. Fungi pose a significant public health concern as they are associated with a wide spectrum of diseases, such as toxic pneumonia, IgE-mediated type I allergies, allergic bronchopulmonary mycosis (ABPM), hypersensitivity pneumonitis, fungal sinusitis, and severe primary or secondary infections in immunocompromised individuals [23,24].
Fungal spores exhibit considerable size variation, ranging from 2–3 μm to 160 μm, with most averaging between 2 and 10 μm. Unicellular spores typically measure 1–10 μm, while small fragments may be less than 1 μm. In contrast, large hyphal fragments and multicellular spores exceed 10 μm in diameter [25]. These variations contribute to their effective atmospheric dispersal and deposition within different regions of the human respiratory tract.
According to Simon-Nobbe et al. [26], more than 100,000 fungal species have been identified to date. However, only a few hundred are known opportunistic pathogens, and approximately 100 species have been described as causative agents of human mycoses [27]. More than 80 fungal species are capable of inducing type I hypersensitivity in atopic individuals, with allergenic proteins identified in 30 fungal genera. Fungal allergy affects an estimated 6–24% of the general population [28,29], up to 44% of atopic individuals [30], and approximately 80% of asthmatic patients [31]. Additionally, 45% of asthmatic children and 70% of asthmatic adults exhibit fungal sensitization [32].
Globally, it is estimated that 1 to 1.5 million fungal species exist, of which nearly 80,000 have been identified. Among these, 112 genera—particularly those within the phyla Ascomycota and Basidiomycota—are considered potential sources of type I allergens [33]. Important allergenic genera within Ascomycota include Alternaria, Aspergillus, Bipolaris, Candida, Cladosporium, Epicoccum, and Phoma. In Basidiomycota, notable allergenic genera include Calvatia, Coprinus, Ganoderma, Pleurotus, and Psilocybe. Type I allergic manifestations commonly present as atopic dermatitis, allergic rhinitis, and allergic asthma [34].
Several genera have been specifically associated with respiratory allergies: Alternaria, Aspergillus, Cladosporium, Helminthosporium, Epicoccum, Aureobasidium, and Penicillium have been linked to allergic asthma. Meanwhile, Alternaria, Aspergillus, Bipolaris, Cladosporium, Curvularia, and Penicillium are frequently implicated in allergic rhinitis [35,36,37,38,39]. Furthermore, Aspergillus allergens play a significant role in the development of ABPA and other Aspergillus-related diseases.
The objectives of the present study were:
- To determine the qualitative and quantitative composition of indoor airborne fungi within the Central Library of Midnapore College (Autonomous).
- To investigate the association between fungal aerospora exposure and allergenic respiratory diseases through a hospitalization survey.
- To assess the allergenicity of dominant fungal species present in the indoor environment using both in vitro and in vivo diagnostic methods.
2. Materials and Methods
2.1. Experimental Procedures
Study Area
For this research, we chose two different intramural environments at the Central Library of Midnapore College (Autonomous), specifically the library’s book storage room and the reading room (Figure 1). The Central Library of Midnapore College is a very old establishment, having existed for over 150 years.

Figure 1.
Map of Midnapore College.
2.2. Methodology
For the present study, the biomonitoring of Aeromycoflora was performed using the Gravimetric Exposure Petri plate method.
Aeromycoflora investigations use a variety of sample approaches, such as the gravity Petri plate technique, which was used by several mycrobiologists [40,41,42,43,44].
Fungal spores can be easily collected and identified using the exposure-Petri plate method. Fungal growth and sporulation were stimulated using the appropriate culture media, i.e., Czapek Dox Agar medium, to increase the quantity of different species of fungi that were present in the air at distinct study locations.
Exposure of Nutrient Media Petri plates was carried out at ambient temperature and humidity in the indoor environment of Midnapore College Library from January 2024 to April 2024 at different intervals by gravimetric technique for 10 min in the library in triplicate and brought into the laboratory and incubated at 25 ± 10 °C for 4–5 days. They were exposed at a height of 2 feet from the floor to avoid dust. The colonies appearing on agar plates were counted (Figure 2) and recorded as a percentage for individual species employing the standard formula [45]. Each exposed plate was triplicated to minimize biological error. One of the Petri plates was not exposed (kept unopened) but incubated with the exposed Petri plates as a control to check if there was any contamination during the preparation of the medium [46].

Figure 2.
The colonies appearing on agar plates were counted in CFU and recorded as a percentage for individual species employing the standard formula.
2.3. Counting of CFUs and Establishing Pure Culture
After three days, fungus colonies begin to stand out on the incubated plates. White mycelia began to show up first, and after a few days, a fully developed fungus CFU was visible. Individual species were identified by counting the fungal colonies (CFUs) that formed in the exposed plates after five to six days. Meanwhile, the CFUs’ color, form, striations, and texture were recorded from both sides. To find the late sporulating CFUs, the colonies were reexamined after 18 days of incubation.
Incubated plates were examined under a binocular stereo microscope to see if there was any overlapping of fungal colonies. CFUs were labeled (numbered) on the Petri plates to track their unique identities. All plates were closely monitored for 45 days. After identifying CFUs and preparing slides and pure cultures, the plates were discarded.
After identification and confirmation of fungi, pure cultures were maintained. Pure cultures of unidentified fungi were also prepared. The inoculation was performed quickly (to avoid contamination) and to obtain the pure cultures under aseptic conditions.
The pure cultures of identified fungi were maintained by continuous subcultures (once every two months) in aseptic conditions and were stored in the laboratory refrigerator.
2.4. Methodological Limitations
The gravity-settled plate method, although widely used for preliminary indoor aeromycological screening due to its simplicity and low cost, has several inherent limitations. It does not permit precise quantification of airborne fungal concentration (CFU/m3), is influenced by airflow and turbulence, and tends to over-represent heavier spores while under-representing lighter or buoyant spores. Furthermore, the absence of a defined sampling volume limits comparability across studies. These limitations have been acknowledged and should be considered when interpreting the exposure data and epidemiological associations.
2.5. Morphological Identification of Fungal Colonies
Identification of different airborne fungi was performed with the help of slides prepared by direct mount from the CFUs. Laboratory experience, fungal spore reference slides (prepared from disease-infected plants), and taxonomic literature by Funder, Ellis et al., and Campbell et al. [47,48,49] helped to identify the fungal taxa.
Identification of fungal flora up to the generic/species level was performed using the following literature sources: [50,51,52,53,54] and other related literatures references.
2.6. Clinical Study, Patient Selection, and Sample Collection
The skin prick test (SPT) with inhalant allergens is the most accurate diagnostic approach for determining if a specific allergen has generated an IgE antibody response and is used to detect IgE antibodies [55]. According to the European Academy of Allergy and Clinical Immunology (EAACI) and the American Academy of Allergy, Asthma, and Immunology (AAAAI), a properly performed prick test is the most convenient and cost-effective way to improve clinical correlation [56,57].
2.7. Patient Selection and Precautions Adopted Before Skin Prick Test
The current study included 38 individuals (N = 38) with respiratory allergies (such as bronchial asthma, allergic rhinitis) and skin allergies (such as atopic dermatitis) aged 18 to 50 years (Figure 3). These patients presented to the Allergy Unit of the Outpatient Department of the Institute of Child Health (ICH) in Kolkata and Mediland Diagnostic, Kolkata, with a variety of symptoms such as cough, breathlessness, sneezing, wheezing, and skin irritation.

Figure 3.
Clinical investigation and collection of hospitalization data.
Precautions
- Patients were not allowed to take any medications for 24 h prior to the skin prick test because certain medications have been shown to reduce skin sensitivity, resulting in false negative results ([56]; AAOA-SPT 2015).
- The diameter of the wheal was measured after 15–20 min. A skin reaction with a wheal diameter of more than 3 mm when compared to the negative control was declared positive. This was to maintain objective assessments of SPT responses [56,57].
2.8. Fungal Pure Culture and Antigen Extraction and Estimation of Total Protein from Spores of Selected Fungus
Preparation of fungal pure culture: Airborne fungal spores were collected using the Petri plate exposure method and impinged on a CDA plate. Repeated sub-culturing of the particular colony on sterile antibiotic-added CDA plates produced pure cultures. CDA (Himedia, Mumbai, India) was produced, sterilized, and loaded with fungal spores. Inoculated broths were kept in an incubator without shaking at 26–28 °C and moderate humidity. A two-week-old culture mat was taken and rinsed in sterile double-distilled water.
Preparation of fungal crude antigenic extract for SPT using phosphate buffer technique [58,59,60].
Aspergillus fumigatus (Af) spores were detected in a notable concentration at both sampling sites where airborne fungal spores were observed. Using a light microscope, the species was identified (Figure 4). Individual colonies were subcultured on sterile PDA plates to produce a pure culture. After ten days, a mycelial mat was extracted and cleaned with sterile double-distilled water. The collected mat was then lyophilized until it was totally dry. A ten-day-old culture’s AF mycelial mat (Figure 5) was standardized to achieve the ideal protein concentration.

Figure 4.
Biodiversity of aeromycoflora of intramural library and reading room of Midnapore College central library (scale bar = 20 µm). (A) Apergillus clavatus; (B) Aspergillus candidus; (C) Aspergillus fumigatus; (D) Aspergillus flavus; (E) Aspergillus glaucus; (F) Aspergillus nidulans; (G) Aspergillus japonicas; (H) Aspergillus niger; (I) Aspergillus versicolor; (J) Drechslera sp.; (K) Epicoccum nigrum; (L) Penicillium citrinum; (M) Penicillium oxalicum; (N) Penicillium chrysogenum; (O) Periconia sp.; (P) Alternaria alternate; (Q) Alternaria solani; (R) Curvularia lunata; (S) Cladosporium cladosporoides; (T) Fusarium solanii; (U) Fusarium oxysporum; (V) Nigrospora sp.
Figure 5.
Aspergillus fumigatus colony.
For the immune-biochemical study, total protein of Aspergillus fumigatus (Af) was isolated following the Tris-phenol extraction method with little modification [61].
2.9. SPT, Sensitivity Grading, Sera Collection, and ELISA (In Vitro Test)
- Skin prick test: The enlisted clinician of the clinics performed a skin prick test (SPT) on sensitive patients with fungal crude antigenic extract (1:10 w/v) to get a general idea about the relationship between allergic symptoms and fungal spore occurrence, using the EAACI method [46].
- Grading of skin reaction is performed after 15–20 min in comparison with the negative control [46,62,63]. Serum samples were taken from sensitive patients for biochemical analysis. The research was conducted at Midland Diagnostics (Kolkata) and the Institute of Child Health (Kolkata).
- Sensitive patients provided written consent to draw 2 mL of blood. Serum was separated and stored at −20 °C for future investigations.
- Sera from two non-atopic individuals were taken as a negative control.
- The individual clinics’ ethical committees authorized the entire study.
Ethics Approval and Consent to Participate
All procedures involving human participants—including clinical recruitment, skin prick testing (SPT), blood collection, and ELISA measurements—were conducted in accordance with the ethical standards of the Institutional Human Ethics Committee. Ethical approval for the study was obtained from the Institutional Ethics Committee of Midnapore College (Autonomous). Written informed consent was obtained from all participants prior to enrollment. The study adhered to the principles of the Declaration of Helsinki (2013 revision).
Indirect ELISA was used to qualitatively detect and quantitatively estimate specific IgE in patient serum (+1 to +3 against Af crude extract) in accordance with the technique [59]. A P/N ratio of more than 2.5 for a given serum was regarded as in vitro “positive,” meaning that the amount of specific IgE was noticeably higher (P and N represent the OD values of the patients and control participants, respectively).
2.10. Sodium Dodecyl Sulfate–Polyacrylamide Gel Electrophoresis (SDS–PAGE) and IgE-Specific Immunoblotting
12% SDS-PAGE was performed for both specific Tris-phenol extraction using a discontinuous buffer system according to Laemmli (1970) [64] (Figure 6). The gel was calibrated with marker protein (GeNeiTM, Bangalore, India).

Figure 6.
Quantitative estimation of specific IgE in patients’ sera against Af allergen through indirect ELISA. (F = Female; M = Male; C = Control subject, P/N = ratio of the OD value for patients by the OD value for control/neutral subjects and P = stands for patient serial number in the experiment).
After the completion of the run, the gel was fixed for one hour in fixing solution (Methanol: Acetic acid: Water = 9:2:9 v/v) and stained for one hour to overnight in 0.25% (w/v) Coomassie Brilliant Blue CBB-R250 prepared in destaining solution (Methanol: Water: Acetic acid = 45:45:10). The gel was documented using Gel Doc 1000 (Bio-Rad, Hercules, CA, USA) using the MOLECULAR ANALYST software (Version 1.4) (Bio-Rad, Hercules, CA, USA). The molecular mass of the protein bands was calculated by calibrating with standard marker proteins (Genei, Bangalore, India).
The proteins separated on SDS-PAGE were electrophoretically transferred to PVDF membrane (Sigma Chemicals, USA), following the method of Karmakar et al. with a Genei Mini-Tank blot apparatus at 4 °C. The immunoblotting was performed on a PVDF membrane according to Sambrook et al. with modification of Sircar et al. [46,59,65]. For the detection of IgE-reactive proteins, the membrane strips were separately incubated overnight (16 h) at 4 °C with serum (primary antibody) samples in 1:10 dilution, collected from individual patients showing positive skin reactions. Membrane strips were then washed in TBST and incubated in secondary antibody (Alkaline phosphatase-conjugated monoclonal antihuman IgE (1:1000), Sigma Chemical Co., St Louis, MS, USA) for 3 h. Binding patterns were visualized by using substrate solution containing nitroblue tetrazolium chloride (NBT) and 5-bromo, 4-chloro, 3 indolyl phosphate potassium salt (BCIP) (Genei, Bangalore, India) in 0.1 M TBS, pH 9.5, and the reaction was stopped by 0.5 M EDTA.
3. Result and Discussion
The microfungal population present in the environment serves as a valuable indicator of the extent of biopollution. Viable microfungal propagules released into the atmosphere may persist within the same environment or disperse over considerable distances. Microbial components in indoor air have attracted increasing attention due to their potential health impacts on a wide range of biological entities, including humans [66]. Exposure to airborne fungal spores has been associated with numerous adverse health effects in both adults and newborns [67].
Conversely, a growing body of empirical evidence supports the hygiene hypothesis, which suggests that early exposure to microbiological agents may actually confer protective benefits and reduce the risk of developing certain diseases later in life [68].
3.1. Aeromycological Sampling: Quantitative and Qualitative Evaluation of the Aerial Fungal Spores
During the monitoring period of January to April 2024, substantial amounts of culturable fungus spores were found in the indoor environment of Midnapore College Library (Figure 2). Different indoor microenvironments revealed a diverse range of mushrooms from different genera. Most of them have been identified as a significant source of aeroallergens that cause respiratory diseases such as severe asthma, cystic fibrosis, allergic rhinitis, anaphylaxis, allergic bronchopulmonary diseases, mycoses, and other respiratory disorders. There is extensive evidence of the relationship between fungal spore concentrations and asthma [69,70,71,72,73]. De Ana et al. found that exposure to high concentrations of Alternaria, Aspergillus, Cladosporium, and Penicillium increased the occurrence of asthma exacerbations by 36% to 48% [74]. Bafadhel et al. discovered that A. fumigatus can cause sensitization in more than 10% of individuals with Chronic Obstructive Pulmonary Disease (COPD) [75]. Furthermore, Aspergillus sp. and Mycobacterium tuberculosis co-infection in the lung of pulmonary tuberculosis (PTB) patients results in additional difficulties [76]. According to Hosseini et al., 15.4% of pulmonary tuberculosis patients in Asia and Africa also have co-infection [77]. Allergenic respiratory diseases have become a big concern around the world. There are 88 allergens in the Phylum Ascomycota, according to the International Union of Immunological Societies (IUIS), whereas 23 species from the Phylum Basidiomycota have been identified as possible allergens. We identified higher concentrations of spores belonging to these phyla in the study area. As a result, the abundance of aeroallergens in the air of the indoor environment of Midnapore College Library may fuel the increasing burden of respiratory disorders and be a possible risk factor for human respiratory trouble.
- Altogether, 815 colonies falling under 15 genera and 28 species have been recorded by the culture plate exposure method (Figure 2). Ascomycota dominated more than half of the colonies recorded, followed by Zygomycota and Deuteromycota, while Oomycota had the fewest colonies. A significant number of colonies prevailed in the onset of summer, while a lesser number occurred in winter during the period of study.
Among the fifteen genera identified, nine are reported to cause serious damage and deterioration of books and paper materials, viz. Mucor, Rhizopus, Aspergillus, Cladosporium, Curvularia, Alternaria, Penicillium, Fusarium, and Epicoccum. The prevailing presence of Aspergilli/Penicilli, Alternaria alternata, Alternaria solani, Cladosporium cladosporoides, Curvularia lunata, Penicillium oxalicum, Epicoccum sp., Fusarium solanii, Fusarium oxysporum, Periconia sp., Rhizopus sp., and Penicillium sp. have been reported to cause allergic manifestations [71,78] and hypersensitivity in visiting students, teaching staff, and book handlers due to inhalation of aeromycobiota (Figure 7 and Figure 8; Table 1).

Figure 7.
The fungal air spora from indoor environment of central library and reading room environment: Ascomycota dominated more than half of the colonies recorded, followed by Zygomycota and Deuteromycota, while Oomycota had the fewest colonies (the occurrence of different groups of fungal spores mentioned in the pie chart is expressed in percentage).

Figure 8.
Graphical presentation of different fungal spore/type concentration collected by the gravimetric Petri plate exposure technique method in the intramural environment of central library of Midnapore College (Autonomous): 28 different types of dominant fungal air spora (total CFU and their percentage contribution during the study period).

Table 1.
Quantitative aeromycoflora in the intramural environment of Midnapore College central library.
- Deuteromycota dominated with 32.14% airspora exhibiting the highest concentrations, followed by Ascomycota with 64.28% air spora. Zygomycota had the least count of 3.58%, while Sterile mycelia contributed 0.74%. Fungal spores from Basidiomycota did not appear on nutrient jelly (Table 1). It is in agreement with the results of Adams et al. (2013) [79], who obtained a higher count of fungal isolates in the indoor environment of a library for Deuteromycota.
- The count of isolates and their concentration in the indoor environment varied with climatic changes. Of the total isolates, Deuteromycota exhibited the highest count of isolates, followed by Ascomycota and Zygomycota. The lowest count of isolates was associated with Sterile mycelia (Figure 7 and Figure 8). Members of Deuteromycota produce enormous resistant thick-walled conidia asexually and remain dormant in an unfavorable indoor environment for a longer duration and are able to germinate on the onset of optimum temperature and high relative humidity [68,80,81].
This is to clarify that the technique was used primarily for qualitative and semi-quantitative assessment of fungal diversity, not for absolute exposure measurement.
These findings are consistent with the results reported by Katre (2016), Kayarkar et al. (2014), Verma et al. (2013) and Lanjewar et al. (2014) [81,82,83,84], who also observed the highest counts of fungal isolates and elevated colony numbers of indoor airborne mycoflora using the gravity plate exposure method. This technique was preferred for the isolation of airborne fungal flora due to its several advantages, as noted by earlier researchers [82,85].
3.1.1. Relationship Between Fungal Spore Concentrations and Atopic Sensitization Among the Visiting Students: Determination of Significant Predictors Through Multiple Regression Model
To evaluate the effect of intramural fungal spore concentrations, symptoms manifestation data on visiting students were collected by periodic visits to the library during the entire monitoring period. From the collected data, it was observed that the maximum number of affected students and staff was recorded in the post-winter season, and the minimum was in the winter season (Figure 9).

Figure 9.
Relationship between fungal spore concentrations and atopic sensitization among the visiting students.
The monthly record of fungal load (CFU) in the central library and its allergic effect on the students and library staff:
- Fungal spore concentration is highest in January due to the dry atmosphere, and gradually decreases from March due to higher temperatures and high moisture content. Thus, fungal spore concentration is positively correlated with temperature and rainfall.
- Exposure to indoor airborne inhalant fungal allergens developed respiratory symptoms and allergies among the students and staff.
3.1.2. The Interpretation of Statistical Analysis (Figure 10)
- R-Squared (R2) equals 0.89. This means that 89% of the variability of % of students and staff suffering due to library visits is explained by the total fungal colonies recorded (Figure 11).
- Correlation (r) equals 0.9485. This means that there is a very strong direct relationship between the total fungal colonies recorded and % of students and staff suffering due to library visits.
- Overall regression: right-tailed, F(1,24) = 215.1586, p-value = 1.765 × 10−13. Since p-value < α (0.05), we reject H0. (Table 2).
 Table 2. Regression ANOVA.
Table 2. Regression ANOVA. - The linear regression model, Y = b0 + b1X + ε, provides a better fit than the model without the independent variable, resulting in Y = b0 + ε.
- The slope (b1): two-tailed, T(24) = 14.6683, p-value = 1.765 × 10−13. For one predictor, it is the same as the p-value for the overall model.
- The y-intercept (b0): two-tailed, T(24) = 1.9595, p-value = 0.06177. Hence, b0 is not significantly different from zero. It is still most likely recommended not to force b0 to be zero.
 Figure 10. Generalized linear regression analysis: The total fungal load in the intramural environment vs. students and staff who visited the library during the study period. The straight line that represents the relationship between a dependent variable (Y) and an independent variable (X) in a linear regression equation.Figure 10. Generalized linear regression analysis: The total fungal load in the intramural environment vs. students and staff who visited the library during the study period. The straight line that represents the relationship between a dependent variable (Y) and an independent variable (X) in a linear regression equation.
Figure 10. Generalized linear regression analysis: The total fungal load in the intramural environment vs. students and staff who visited the library during the study period. The straight line that represents the relationship between a dependent variable (Y) and an independent variable (X) in a linear regression equation.Figure 10. Generalized linear regression analysis: The total fungal load in the intramural environment vs. students and staff who visited the library during the study period. The straight line that represents the relationship between a dependent variable (Y) and an independent variable (X) in a linear regression equation.
 Figure 11. Total fungal colonies recorded predicted % of Students and staff suffering due to library visit, R2 = 0.89, F(1,24) = 237.68, p < 0.001, β = 0.14, p < 0.001, α = 0.7, p = 0.052.Figure 11. Total fungal colonies recorded predicted % of Students and staff suffering due to library visit, R2 = 0.89, F(1,24) = 237.68, p < 0.001, β = 0.14, p < 0.001, α = 0.7, p = 0.052.
Figure 11. Total fungal colonies recorded predicted % of Students and staff suffering due to library visit, R2 = 0.89, F(1,24) = 237.68, p < 0.001, β = 0.14, p < 0.001, α = 0.7, p = 0.052.Figure 11. Total fungal colonies recorded predicted % of Students and staff suffering due to library visit, R2 = 0.89, F(1,24) = 237.68, p < 0.001, β = 0.14, p < 0.001, α = 0.7, p = 0.052.
Regression line equation:
Ŷ = 0.7046 + 0.1417X
3.2. Selection of Fungal Species for Immune-Biochemical Analysis
Among various species of the two selected predominant culturable fungi found in the intramural environment of the Midnapore College Library, Aspergillus fumigatus (Af) was chosen for further study due to its higher frequency in the library and ability to induce IgE-sensitization in atopic patient sera, as observed in the skin prick test.
On Czapek Dox agar, colonies are typically blue-green with a suede-like surface consisting of a dense felt of conidiophores. It produces white, yellow, yellow-brown, brown to black, or green-colored colonies. Very mature colonies turn slate gray. On Czapek Dox agar at 25 °C, it produces colonies of 4 ± 1 cm within a week. Texture is woolly to cottony to somewhat granular. Colonies on Czapek Dox agar are usually blue-green with a suede-like surface made up of a dense felt of conidiophores. It produces white, yellow, yellow-brown, brown to black, or green colonies. Mature colonies turn slate grey.
3.2.1. Allergenicity Assessment by Skin Prick Test
As shown in Table 3, a total of 38 patients presenting with various respiratory problems were evaluated for sensitization to multiple fungal species. Among the fungi tested, species of Aspergillus exhibited the highest sensitization rates. A. fumigatus was identified as the most sensitizing species, with a sensitization frequency of 39.5%.

Table 3.
List of fungal species and their degree of sensitivity in different grades in SPT (Skin Prick Test).
3.2.2. Specific IgE Estimation
Indirect ELISA was performed to determine the specific IgE titer in the patient’s sera against the crude antigenic extract of Af.
Four patients’ sera and two non-allergic sera as controls were tested against Af crude fungal extracts. The P/N value was obtained in the range of 2.46 to 3.47 (Figure 6).
3.2.3. Immuno-Biochemical Study of Mycelial Crude Proteins/Antigens
On reducing SDS-PAGE (12%), the Tris phenol extract (Lane A) of Aspergillus fumigatus resolved into more than 20 distinct bands between 15.5 kDa and 112.3 kDa, while protein fractions of 102.3, 98.7, 69.2, 62.2, 57.4, 52.3, 50.5, 45.1, 42.3, 37.2, 35.1, 33.6, 28.9, 24.5, 22.5, 21.6, 17.9 and 15.5 kDa were most prominent and stained strongly with Coomassie brilliant blue in both the lanes. Some of the bands, ranging from molecular weight 45.1 to 110.8 kDa, were less distinct but sharp. Other bands were weak and less stained but were clearly visible and distinguishable on the gel (Figure 12).

Figure 12.
12% SDS-PAGE of Tris-phenol fraction fungal mycelial protein extracts resolved into multiple and distinct protein bands. Lane M: Mol. Wt. Marker; Lane A: Aspergillus fumigatus crude protein.
3.2.4. IgE-Specific Immunoblotting
In the ELISA assay, sera from two patients exhibited a P/N ratio greater than two (Table 4), indicating a positive IgE-mediated response to Aspergillus fumigatus antigen. These two sera (P12 and P23), both sensitized to A. fumigatus, were subsequently selected for IgE-specific immunoblotting to identify immunoreactive protein components present in the fungal extract.

Table 4.
Quantitative chemical analysis (conc. of protein) of selected fungal antigen.
Immunoblot analysis revealed seven distinct IgE-binding protein fractions corresponding to molecular weights of 21.6, 22.5, 24.5, 35.1, 37.2, 50.5, and 62.2 kDa (Figure 13). Among the higher molecular weight proteins, the 62.2 kDa band demonstrated IgE reactivity with both patient sera. In contrast, the 21.6 kDa band, one of the lower molecular weight proteins, was recognized by specific IgE antibodies in the majority of the tested sera.

Figure 13.
IgE-specific immunoblotting with Aspergillus fumigatus antigen. Lane M: molecular weight markers expressed in kDa; Numbered lanes: immunoblots using serum from individual patients sensitized to Af fungal antigen, and Lane C: immunoblot using control serum.
Three IgE-reactive components—22.5 kDa, 35.1 kDa, and 50.5 kDa—were consistently present in both patient samples, indicating a 100% binding frequency and suggesting that these proteins may represent dominant allergenic fractions of A. fumigatus in this study population. Other reactive components (21.6, 24.5, 37.2, and 62.2 kDa) exhibited lower but still noteworthy sensitization frequencies.
Collectively, these results identify several previously uncharacterized IgE-binding proteins of Aspergillus fumigatus, indicating their potential role as novel aeroallergens capable of eliciting immediate hypersensitivity responses upon inhalation.
4. Conclusions
The indoor aeromycoflora of libraries is known to play a significant role not only in triggering allergies and other airborne disorders but also in contributing to the deterioration of both cellulosic and non-cellulosic library materials. The identification and characterization of these fungal allergens—using advanced immunological techniques such as immunoblotting—provide crucial insights into their biochemical composition, allergenic potential, and epidemiological importance. Biomonitoring data from the present study revealed that *Aspergillus fumigatus* spores were present in substantial concentrations within the indoor air environment.
Seasonal analysis demonstrated that fungal spore concentrations peaked in January, coinciding with the dry climatic conditions typical of that period. Spore levels gradually declined from March onward, likely due to increasing temperatures and higher atmospheric moisture. These observations indicate a positive correlation between environmental factors—particularly temperature and rainfall—and the concentration of airborne fungal spores.
Aspergillus fumigatus is among the most widespread and abundant airborne saprophytic fungi. As a dominant member of the Aspergillus group, it is frequently encountered in both indoor and outdoor environments. Because its conidia are readily aerosolized, they are regularly inhaled by humans and animals, making this species particularly important from a clinical and public health perspective.
More than 80 fungal genera have been identified containing the allergenic potential to induce respiratory allergic reactions in susceptible individuals in previous studies [17,24,67]. Meanwhile, we found almost 28 different types of fungal spores, depending on their morphological study. One of the most predominant groups of fungi is the Aspergillus group, of which more than 70 different classes of proteins have been reported as potent aeroallergens. This saprophytic genus represents a dominant indoor pathogen [86,87]. They can produce a large quantity of conidiospores of 2–3 μm. Hence, upon inhalation, they can easily reach the terminal airway or upper respiratory tract, where they are deposited in the form of large clusters [59,86,87,88].
The allergenicity of Aspergillus fumigatus fungal spores, being one of the predominant types, was first checked by SPT. In SPT, 39.5% of atopic individuals were found to be allergic to this fungal spore. Up to 44% of atopic patients [30] and 80% of asthmatic patients [31] are also affected by it, whereas 45% of asthmatic children and 70% of asthmatic adults [32] are affected by fungal allergies.
In addition, the World Allergy Organization (WAO) has stated that the skin prick test (SPT) is the most effective initial screening method for detecting IgE-mediated sensitization [55]. Following SPT, allergenicity was further confirmed by measuring serum-specific IgE levels from blood samples collected from willing patients. Clinical surveys indicated that many atopic asthma patients experienced recurrent asthma attacks during the months between January and March.
To evaluate the effect of intramural fungal spore concentrations on individuals visiting the library, data were collected through regular monitoring throughout the study period. Analysis of the collected data revealed that the highest numbers of affected students and staff were reported during the post-winter season, while the lowest cases occurred during winter. Statistical evaluation showed that approximately 90% of the variability in the number of symptomatic individuals was explained by the total fungal colony counts recorded, suggesting a strong association between indoor fungal load and adverse health impacts.
For detailed clinico-immunological analysis, the fungal proteome was initially separated using one-dimensional SDS-PAGE. IgE-specific immunoblotting was then performed to identify seroreactive allergenic proteins. Several distinct immunoreactive bands were observed in the 1D immunoblot, indicating the presence of multiple IgE-binding components.
In conclusion, the present study is a combinational approach that includes an aerobiological study to check the prevalence of Aspergillus fumigatus fungal spores, followed by in vivo and in vitro checking of its allergenicity, and finally a detailed proteomic study to detect allergenic proteins. The aerobiological study found the Aspergillus fumigatus fungal spore to be prevalent from January to March. Immunoblotting stands as a cornerstone in the comprehensive analysis of aeromycoflora allergens, offering a precise and sensitive approach to identify and characterize fungal allergens responsible for respiratory allergies. As our understanding of aeromycoflora and its impact on human health continues to evolve, the continued refinement and application of immunoblotting techniques will play a pivotal role in advancing allergy research and enhancing clinical management strategies. The effect of airborne fungal spores on human health is also a point of concern, which could be studied by the use of preliminary data provided in this research article. Exposure to indoor airborne inhalant mold allergens develops respiratory symptoms, airway disorders, and allergies.
This report can be used to improve the intramural environment of the library by fumigating the bookshelves regularly to check the uncontrolled spread of fungal spores, which may cause deterioration as well as serious health impacts on the college students and library staff.
Study Limitations
The sample size for ELISA (n = 4) and IgE-specific immunoblotting (n = 2) was limited by participant availability and willingness to provide blood samples. As such, the immunological findings should be interpreted as preliminary indicators rather than population-level estimates. Future studies with larger clinical cohorts are necessary to validate the allergenic components identified.
Author Contributions
Conceptualization, T.B.; methodology, T.B., R.P., A.M., and A.R.; software: T.B.; validation, R.P., A.M., A.R., and T.B.; formal analysis, T.B.; data curation, T.B.; writing—original draft preparation, T.B., A.M., and A.R.; writing—T.B. and R.P.; visualization, T.B. and R.P.; supervision, T.B.; project administration, T.B. All authors have read and agreed to the published version of the manuscript.
Funding
This research received funding from RUSA (Rashtriya Uchchatar Shiksha Abhiyan, which translates to National Higher Education Campaign) component 2.0 by the Govt. of India (approval letter No. 355/MC/MRP/RUSA-2.0/21(12/14); Dated: 16 March 2021).
Institutional Review Board Statement
The study was conducted in accordance with the Declaration of Helsinki, and approved by the Ethics Committee of MIDNAPORE COLLEGE (Autonomous), and the date of approval was on 23 March 2024 (we don’t have any protocol code). Ethical review and approval were waived for this study because it was conducted in a clinic by an expert physician, and clinical data and serum samples were obtained from the expert.
Informed Consent Statement
Informed consent was obtained from all subjects involved in the study.
Data Availability Statement
Data sharing is not applicable to this article.
Acknowledgments
We acknowledge the faculties of the Department of Botany, the Teacher-in-charge (Head of the Institution) of this college. The immense support of the laboratory staff of the college should be acknowledged. We acknowledge Akhil Pandey for his help in allowing to use the Microbiology laboratory for fungal culture and identification.
Conflicts of Interest
The authors declare no conflicts of interest.
References
- Kalaskar, P.G.; Zodpe, S.N. Biodeterioration of Library Resources and Possible Approaches for Their Control. Int. J. Appl. Res. 2016, 2, 25–33. [Google Scholar]
- Adams, J. Analysis of Printing and Writing Papers by Using Direct Analysis in Real Time Mass Spectrometry. Int. J. Mass Spectrom. 2011, 301, 109–126. [Google Scholar] [CrossRef]
- Byers, B. A Simple and Practical Fumigation System. Newsletter 1983, 7, 1–4. [Google Scholar]
- Maggi, O.; Persiani, A.M.; Gallo, F.; Valenti, P.; Pasquariello, G.; Sclocchi, M.C.; Scorrano, M. Airborne Fungal Spores in Dust Present in Archives: Proposal for a Detection Method New for Archival Materials. Aerobiologia 2000, 16, 429–434. [Google Scholar] [CrossRef]
- Koestler, R.J. When Bad Things Happen to Good Art. Int. Biodeterior. Biodegrad. 2000, 46, 259–260. [Google Scholar] [CrossRef]
- Shamsian, A.; Fata, A.; Mohajeri, M.; Ghazvini, K. Fungal Contaminations in Historical Manuscripts at Astan Quds Museum Library, Mashhad, Iran. Int. J. Agric. Biol. 2008, 8, 420–422. [Google Scholar]
- Bankole, O.M. A Review of Biological Deterioration of Library Materials and Possible Control Strategies in the Tropics. Lib. Rev. 2010, 59, 414–429. [Google Scholar] [CrossRef]
- Guggenheim, S.; Martin, R.T. Definition of Clay and Clay Mineral: Journal Report of the AIPEA Nomenclature and CMS Nomenclature Committees. Clays Clay Miner. 1995, 43, 255–256. [Google Scholar] [CrossRef]
- Bhattacharya, K.; Raha, S.; Majumdar, M.R. Measuring Indoor Fungal Contaminants in Rural West Bengal, India, with Reference to Allergic Symptoms. Indoor Built Environ. 2001, 10, 40–47. [Google Scholar] [CrossRef]
- Mabee, W.; Roy, D.N. Modeling the Role of Paper Mill Sludge in the Organic Carbon Cycle of Paper Products. Environ. Rev. 2003, 11, 1–16. [Google Scholar] [CrossRef]
- Lugauskas, A.; Kriktaponis, A. Microscopic Fungi Found in the Libraries of Vilnius and Factors Affecting Their Development. Indoor Built Environ. 2004, 13, 169–182. [Google Scholar] [CrossRef]
- Doncea, S.M.; Ion, R.M.; Fierascui, R.C.; Bacalum, E.; Bunaciu, A.A.; Aboul-Enein, H.Y. Spectral Methods for Historical Paper Analysis: Composition and Age Approximation. Instrum. Sci. Technol. 2010, 38, 96–106. [Google Scholar] [CrossRef]
- Area, M.C.; Cheradame, H. Paper Aging and Degradation: Recent Findings and Research Methods. Bioresources 2011, 6, 5307–5337. [Google Scholar] [CrossRef]
- Karbowska-Berent, J.; Górny, R.L.; Strzelczyk, A.B.; Wlazło, A. Airborne and Dust-Borne Microorganisms in Selected Polish Libraries and Archives. Build. Environ. 2011, 46, 1872–1879. [Google Scholar] [CrossRef]
- Furlong-Silva, J.; Cook, P.C. Fungal-mediated lung allergic airway disease: The critical role of macrophages and dendritic cells. PLoS Pathog. 2022, 18, e1010608. [Google Scholar] [CrossRef]
- Henniges, U.; Schiehsser, S.; Ahn, K.; Hofinger, A.; Geschke, A.; Potthast, A.; Rosenau, T. On the Structure of the Active Compound in Mass Deacidification of Paper. Holzforschung Int. J. Biol. Chem. Phys. Technol. Wood 2012, 66, 447–450. [Google Scholar] [CrossRef]
- Karmakar, B.; Sen Gupta, K.; Kaur, A.; Roy, A.; Gupta-Bhattacharya, S. Fungal Bioaerosol in Multiple Micro-Environments from Eastern India: Source, Distribution, and Health Hazards. SN Appl. Sci. 2020, 2, 565. [Google Scholar] [CrossRef]
- Kowalik, R. Microbiodeterioration of Library Materials. Part 1. Restaurator 1980, 4, 99–114. [Google Scholar] [CrossRef]
- Zyska, B. Fungi Isolated from Library Materials: A Review of the Literature. Int. Biodeterior. Biodegrad. 1997, 40, 43–51. [Google Scholar] [CrossRef]
- Majumdar, M.R.; Hazare, S. Assessment of Fungal Contaminants in the Libraries of Presidency College, Kolkata. Indian. J. Aerobiol. 2005, 18, 1–5. [Google Scholar]
- Adhikari, A.; Sen, M.M.; Gupta-Bhattacharya, S.; Chanda, S. Airborne viable, non-viable, and allergenic fungi in a rural agricultural area of India: A 2-year study at five outdoor sampling stations. Sci. Total Environ. 2004, 326, 123–141. [Google Scholar] [CrossRef]
- Majumdar, M.R.; Bhattacharya, K. Measurement of Indoor Fungal Contaminants Causing Allergy among the Workers of Paper Related Industries of West Bengal, India. Indoor Built Environ. 2004, 13, 189–197. [Google Scholar] [CrossRef]
- Kauffman, H.F.; Tomée, J.F.; van de Riet, M.A.; Timmerman, A.J.; Borger, P. Protease-Dependent Activation of Epithelial Cells by Fungal Allergens Leads to Morphologic Changes and Cytokine Production. J. Allergy Clin. Immunol. 2000, 105, 1185–1193. [Google Scholar] [CrossRef] [PubMed]
- Fischer, G.; Schwalbe, R.; Möller, M.; Ostrowski, R.; Dott, W. Species-Specific Production of Microbial Volatile Organic Compounds (MVOCs) by Airborne Fungi from a Compost Facility. Chemosphere 1999, 39, 795–810. [Google Scholar] [CrossRef] [PubMed]
- Yamamoto, N.; Bibby, K.; Qian, J.; Hospodsky, D.; Rismani-Yazdi, H.; Nazaroff, W.W.; Peccia, J. Particle-Size Distributions and Seasonal Diversity of Allergenic and Pathogenic Fungi in Outdoor Air. ISME J. 2012, 6, 1801–1811. [Google Scholar] [CrossRef]
- Simon-Nobbe, B.; Denk, U.; Poll, V.; Rid, R.; Breitenbach, M. The Spectrum of Fungal Allergy. Int. Arch. Allergy Immunol. 2008, 145, 58–86. [Google Scholar] [CrossRef]
- De Hoog, G.S.; Guarro, J.; Gene, J.; Figueras, M.J. Atlas of Clinical Fungi, 2nd ed.; Centraalbureau voor Schimmelcultures: Utrecht, The Netherlands, 2000. [Google Scholar]
- Tariq, S.M.; Matthews, S.M.; Stevens, M.; Hakim, E.A. Sensitization to Alternaria and Cladosporium by the Age of 4 Years. Clin. Exp. Allergy 1996, 26, 794–798. [Google Scholar] [CrossRef]
- Salvaggio, J.; Aukrust, L. Postgraduate Course Presentations. Mold-Induced Asthma. J. Allergy Clin. Immunol. 1981, 68, 327–346. [Google Scholar] [CrossRef]
- Corey, J.P.; Kaiseruddin, S.; Gungor, A. Prevalence of Mold-Specific Immunoglobulins in a Midwestern Allergy Practice. Otolaryngol. Head Neck Surg. 1997, 123, 283–289. [Google Scholar]
- Lopez, M.; Salvaggio, J.E. Mold-Sensitive Asthma. Clin. Rev. Allergy 1985, 3, 183–196. [Google Scholar] [CrossRef]
- Hsieh, K.H.; Shen, J.J. Prevalence of childhood asthma in Taipei, Taiwan, and other Asian Pacific countries. J. Asthma 1988, 25, 73–82. [Google Scholar] [CrossRef] [PubMed]
- Teresa, E.T.; Curin, M.; Valenta, R.; Swoboda, I. Mold Allergens in Respiratory Allergy: From Structure to Therapy. Allergy Asthma Immunol. Res. 2015, 7, 205–220. [Google Scholar]
- Kortekangas-Savolainen, O.; Lammintausta, K.; Kalimo, K. Skin Prick Test Reactions to Brewer’s Yeast (Saccharomyces cerevisiae) in Adult Atopic Dermatitis Patients. Allergy 1993, 48, 147–150. [Google Scholar] [CrossRef] [PubMed]
- Denning, D.W.; O’Driscoll, B.R.; Hogaboam, C.M.; Bowyer, P.; Niven, R.M. The Link between Fungi and Severe Asthma: A Summary of the Evidence. Eur. Respir. J. 2006, 27, 615–626. [Google Scholar] [CrossRef]
- Bush, R.K.; Prochnau, J.J. Alternaria-Induced Asthma. J. Allergy Clin. Immunol. 2004, 113, 227–234. [Google Scholar] [CrossRef]
- Neukirch, C.; Henry, C.; Leynaert, B.; Liard, R.; Bousquet, J.; Neukirch, F. Is Sensitization to Alternaria alternata a Risk Factor for Severe Asthma? A Population-Based Study. J. Allergy Clin. Immunol. 1999, 103, 709–711. [Google Scholar] [CrossRef]
- Niedoszytko, M.; Chelminska, M.; Jassem, E.; Czestochowska, E. Association between Sensitization to Aureobasidium pullulans (Pullularia sp.) and Severity of Asthma. Ann. Allergy Asthma Immunol. 2007, 98, 153–156. [Google Scholar] [CrossRef]
- Kumar, A.; Reddy, L.V.; Sochanik, A.; Kurup, V.P. Isolation and Characterization of a Recombinant Heat Shock Protein of Aspergillus fumigatus. J. Allergy Clin. Immunol. 1993, 91, 1024–1030. [Google Scholar] [CrossRef]
- Licorish, K.; Novey, H.S.; Kozak, P.; Fairshter, R.D.; Wilson, A.F. Role of Alternaria and Penicillium Spores in the Pathogenesis of Asthma. J. Allergy Clin. Immunol. 1998, 76, 819–825. [Google Scholar] [CrossRef]
- Larsen, L.S. A Three-Year Survey of Micro Fungi in the Air of Copenhagen. Allergy 1981, 36, 15–22. [Google Scholar] [CrossRef]
- Nussbaum, F. Variation in the airborne fungal spore population of the Tuscarawas Valley II. Mycopathologia 1991, 116, 181–198. [Google Scholar] [CrossRef]
- Abdel-Hafez, S.I.I.; El-Said, A.H.M.; Gherbawy, Y.A.M.H. Mycoflora of leaf surface, stem, bagasse, and juice of adult sugarcane (Saccharum officinarum L.) plant and cellulolytic ability in Egypt. Bull. Fac. Sci. Assiut Univ. 1995, 24, 113–130. [Google Scholar]
- Shams-Ghahfarokhi, M.; Aghaei-Gharehbolagh, S.; Aslani, N.; Razzaghi-Abyaneh, M. Investigation on distribution of airborne fungi in outdoor environment in Tehran, Iran. J. Environ. Health Sci. Eng. 2014, 12, 1–7. [Google Scholar] [CrossRef] [PubMed]
- Kalbende, S.; Dalal, L.; Bhowal, M. The Monitoring of Airborne Mycoflora in Indoor Air Quality of Library. J. Nat. Prod. Plant Resour. 2012, 2, 675–679. [Google Scholar]
- Karmakar, B.; Saha, B.; Jana, K.; Gupta Bhattacharya, S. Identification and biochemical characterization of Asp t 36, a new fungal allergen from Aspergillus terreus. J. Biol. Chem. 2020, 295, 17852–17864. [Google Scholar] [CrossRef]
- Agarwal, M.K.; Shivpuri, D.N.; Mukerji, K.G. Studies on the allergenic fungal spores of the Delhi, India, metropolitan area. J. Allergy 1969, 44, 193–203. [Google Scholar] [CrossRef]
- Ellis, M.B.; Ellis, J.P. Fungi without Gills (Hymenomycetes and Gasteromycetes): An Identification Handbook; Chapman and Hall: London, UK, 1990. [Google Scholar]
- Campbell, C.; Johnson, E.M. Identification of Pathogenic Fungi; Wiley: London, UK, 2013. [Google Scholar]
- Sreeramulu, T.; Ramalingam, A. A Two-Year Study of the Air-Spore of a Paddy Field near Visakhapatnam. Indian J. Agric. Sci. 1966, 36, 111–132. [Google Scholar]
- Ainsworth, G.C.; Sparrow, F.K.; Sussman, A.S. The fungi, an advanced treatise. Yale J. Biol. Med. 1973, 38, 485–486. [Google Scholar]
- El Jaddaoui, I.; Ghazal, H.; Bennett, J.W. Mold in Paradise: A Review of Fungi Found in Libraries. J. Fungi 2023, 9, 1061. [Google Scholar] [CrossRef]
- Singh, B.; Singh, S.; Asif, A.R.; Oellerich, M.; Sharma, G.L. Allergic Aspergillosis and the Antigens of Aspergillus fumigatus. Curr. Protein Pept. Sci. 2014, 15, 403–423. [Google Scholar] [CrossRef]
- Sengupta, K.; Karmakar, B.; Gupta-Bhattacharya, S. A Comparative Study on Airborne Non-Viable and Viable Fungal Spores of Urban and Rural Area of the Gangetic Plains of West Bengal through Aerobiological Survey. Indian J. Aerobiol. 2015, 28, 1–13. [Google Scholar]
- Pawankar, R.; Canonica, G.; Holgate, S.; Lockey, R. WAO White Book on Allergy; World Allergy Organization: Milwaukee, WI, USA, 2012. [Google Scholar]
- Heinzerling, L.; Meri, A.; Bergmann, K.C.; Bresciani, M.; Burbach, G.; Darsow, U. The Skin Prick Test—European Standards. Clin. Transl. Allergy 2013, 3, 3. [Google Scholar] [CrossRef] [PubMed]
- Bernstein, I.L.; Li, J.T.; Bernstein, D.I.; Hamilton, R.; Spector, S.L.; Tan, R. Allergy Diagnostic Testing: An Updated Practice Parameters. Ann. Allergy Asthma Immunol. 2018, 103, S1–S148. [Google Scholar] [CrossRef] [PubMed]
- Fatteh, S.; Rekkerth, D.J.; Hadley, J.A. Skin prick/puncture testing in North America: A call for standards and consistency. Allergy Asthma Clin Immunol. 2014, 10, 44. [Google Scholar] [CrossRef]
- Sircar, G.; Bhowmik, M.; Sarkar, R.K.; Najafi, N.; Dasgupta, A.; Focke-Tejkl, M.; Flicker, S.; Mittermann, I.; Valenta, R.; Bhattacharya, K.; et al. Molecular characterization of a fungal cyclophilin allergen Rhi o 2 and elucidation of antigenic determinants responsible for IgE–cross-reactivity. J. Biol. Chem. 2020, 295, 2736–2748. [Google Scholar] [CrossRef]
- Dreborg, S. Methods for Skin Testing. Allergy 1989, 44, 22–30. [Google Scholar]
- Sircar, G.; Saha, B.; Mandal, R.S.; Pandey, N.; Saha, S.; Bhattacharya, S.G. Purification, Cloning and Immuno-Biochemical Characterization of a Fungal Aspartic Protease Allergen Rhi o 1 from the Airborne Mold Rhizopus oryzae. PLoS ONE 2015, 10, e0144547. [Google Scholar] [CrossRef]
- Shivpuri, D.N. Clinically Important Pollen, Fungal and Insect Allergens for Nasobronchial Allergy Patients in India. Asp. Allergy Appl. Immunol. 1980, 13, 19–23. [Google Scholar]
- Singh, B.; Oellerich, M.; Kumar, R.; Kumar, M.; Bhadoria, D.P.; Reichard, U.; Gupta, V.K.; Sharma, G.L.; Asif, A.R. Immuno-reactive molecules identified from the secreted proteome of Aspergillus fumigatus. J. Proteome Res. 2010, 9, 5517–5529. [Google Scholar] [CrossRef]
- Laemmli, U.K. Cleavage of structural proteins during the assembly of the head of bacteriophage T4. Nature 1970, 227, 680–685. [Google Scholar] [CrossRef]
- Sambrook, J.; Russell, D.W. Molecular Cloning: A Laboratory Manual, 4th ed.; Cold Spring Harbor Laboratory Press: Cold Spring Harbor, NY, USA, 2012. [Google Scholar]
- Chelak, E.P.; Sharma, K. Aeromycological Study of Chandragiri Hill Top, Chhattisgarh. Int. Multidiscip. Res. J. 2012, 2, 15–16. [Google Scholar]
- Karvala, K.; Toskala, E.; Luukkonen, R.; Lappalainen, S.; Uitti, J.; Nordman, H. New-Onset Adult Asthma in Relation to Damp and Moldy Workplaces. Int. Arch. Occup. Environ. Health 2010, 83, 855–865. [Google Scholar] [CrossRef] [PubMed]
- Roy, S.; Saha, B.; Bhattacharya, S.B. Identifying novel allergens from a common indoor mould Aspergillus ochraceus. J. Proteom. 2021, 238, 104156. [Google Scholar] [CrossRef] [PubMed]
- Oliveira, M.; Ribeiro, H.; Delgado, J.L.; Abreu, I. The Effect of Meteorological Factors on Airborne Fungal Spore Concentration in Two Areas Differing in Urbanisation Level. Int. J. Biometeorol. 2009, 53, 61–73. [Google Scholar] [CrossRef] [PubMed]
- Nambu, M.; Kouno, H.; Aihara-Tanaka, M.; Shirai, H.; Takatori, K. Detection of Fungi in Indoor Environments and Fungus-Specific IgE Sensitization in Allergic Children. World Allergy Organ. J. 2009, 2, 208–212. [Google Scholar] [CrossRef]
- Denning, D.W.; Pashley, C.; Hartl, D.; Wardlaw, A.; Godet, C.; Di Giacco, S.; Sergejeva, S. Fungal Allergy in Asthma—State of the Art and Research Needs. Clin. Transl. Allergy 2014, 4, 14. [Google Scholar] [CrossRef]
- Crameri, R.; Garbani, M.; Rhyner, C.; Huitema, C. Fungi: The Neglected Allergenic Sources. Allergy 2014, 69, 176–185. [Google Scholar] [CrossRef]
- Ahmed, A.; Christy Sadreameli, S.; Curtin-Brosnan, J.; Grant, T.; Phipatanakul, W.; Perzanowski, M.; Balcer-Whaley, S.; Peng, R.; Newman, M.; Cunningham, A.; et al. Do Baseline Asthma and Allergic Sensitization Characteristics Predict Responsiveness to Mouse Allergen Reduction? J. Allergy Clin. Immunol. Pract. 2020, 8, 596–602. [Google Scholar] [CrossRef]
- de Ana, S.G.; Torres-Rodriguez, J.M.; Ramírez, E.A. Seasonal Distribution of Alternaria, Aspergillus, Cladosporium and Penicillium Species Isolated in Homes of Fungal Allergic Patients. J. Investig. Allergol. Clin. Immunol. 2006, 16, 357–363. [Google Scholar]
- Bafadhel, M.; Greening, N.J.; Harvey-Dunstan, T.C.; Williams, J.E.; Morgan, M.D.; Brightling, C.E.; Hussain, S.F.; Pavord, I.D.; Singh, S.J.; Steiner, M.C. Blood Eosinophils and Outcomes in Severe Hospitalized Exacerbations of COPD. Chest 2016, 150, 320–328. [Google Scholar] [CrossRef]
- Xerinda, S.; Neves, N.; Santos, L.; Sarmento, A. Endotracheal Tuberculosis and Aspergillosis Coinfection Manifested as Acute Respiratory Failure: A Case Report. Bioresources 2011, 6, 2435–2447. [Google Scholar]
- Hosseini, M.; Shakerimoghaddam, A.; Ghazalibina, M.; Khaledi, A. Aspergillus Coinfection among Patients with Pulmonary Tuberculosis in Asia and Africa Countries: A Systematic Review and Meta-Analysis of Cross-Sectional Studies. Microb. Pathog. 2020, 141, 104018. [Google Scholar] [CrossRef] [PubMed]
- Chakrabarti, H.S.; Das, S.; Gupta-Bhattacharya, S. Outdoor Airborne Fungal Spora Load in a Suburb of Kolkata, India: Its Variation, Meteorological Determinants and Health Impact. Int. J. Environ. Health Res. 2012, 22, 37–50. [Google Scholar] [CrossRef] [PubMed]
- Adams, R.I.; Miletto, M.; Taylor, J.W.; Bruns, T.D. The diversity and distribution of fungi on residential surfaces. PLoS ONE 2013, 8, e78866. [Google Scholar] [CrossRef]
- Jyoti, J.; Malik, C.P. Seed Deterioration: A Review. Int. J. Life Sci. Biotechnol. Pharm. Res. 2013, 2, 373–386. [Google Scholar]
- Katre, J. Studies on Aeromycology of Railway Station, Nagpur. Master’s Thesis, P.G. Dept. of Botany, R.T.M. Nagpur University, Nagpur, India, 2016. [Google Scholar]
- Kayarkar, A.; Bhajbhuje, M.N. Biodiversity of Aeromycoflora from Indoor Environment of Library. Int. J. Life Sci. 2014, A2, 21–24. [Google Scholar]
- Verma, S.; Thakur, B.; Karkun, D.; Shrivastav, R. Studies of Aeromycoflora of District and Session Court of Durg, Chhattisgarh. J. Bio. Innov. 2013, 2, 146–151. [Google Scholar]
- Lanjewar, S.; Sharma, K. Intramural Aeromycoflora of Rice Mill of Chhattisgarh. DAMA Int. 2014, 1, 39–45. [Google Scholar]
- Dongre, P.; Bhajbhuje, M.N. Biodiversity of Fungal Flora of Outdoor Environment of Botanical Garden; P.G. Dept. of Botany, R.T.M. Nagpur University: Nagpur, India, 2015. [Google Scholar]
- Horner, W.E.; Helbling, A.; Salvaggio, J.E.; Lehrer, S.B. Fungal Allergens. Clin. Microbiol. Rev. 1995, 8, 161–179. [Google Scholar] [CrossRef]
- Kurup, V.P.; Shen, H.-D.; Banerjee, B. Respiratory Fungal Allergy. Microbes Infect. 2000, 2, 1101–1110. [Google Scholar] [CrossRef]
- Kurup, V.P. Fungal Allergy. In Handbook of Fungal Biotechnology; Arora, N., Ed.; Dekker: New York, NY, USA, 2003; pp. 515–525. [Google Scholar]
Disclaimer/Publisher’s Note: The statements, opinions and data contained in all publications are solely those of the individual author(s) and contributor(s) and not of MDPI and/or the editor(s). MDPI and/or the editor(s) disclaim responsibility for any injury to people or property resulting from any ideas, methods, instructions or products referred to in the content. |
© 2026 by the authors. Licensee MDPI, Basel, Switzerland. This article is an open access article distributed under the terms and conditions of the Creative Commons Attribution (CC BY) license.